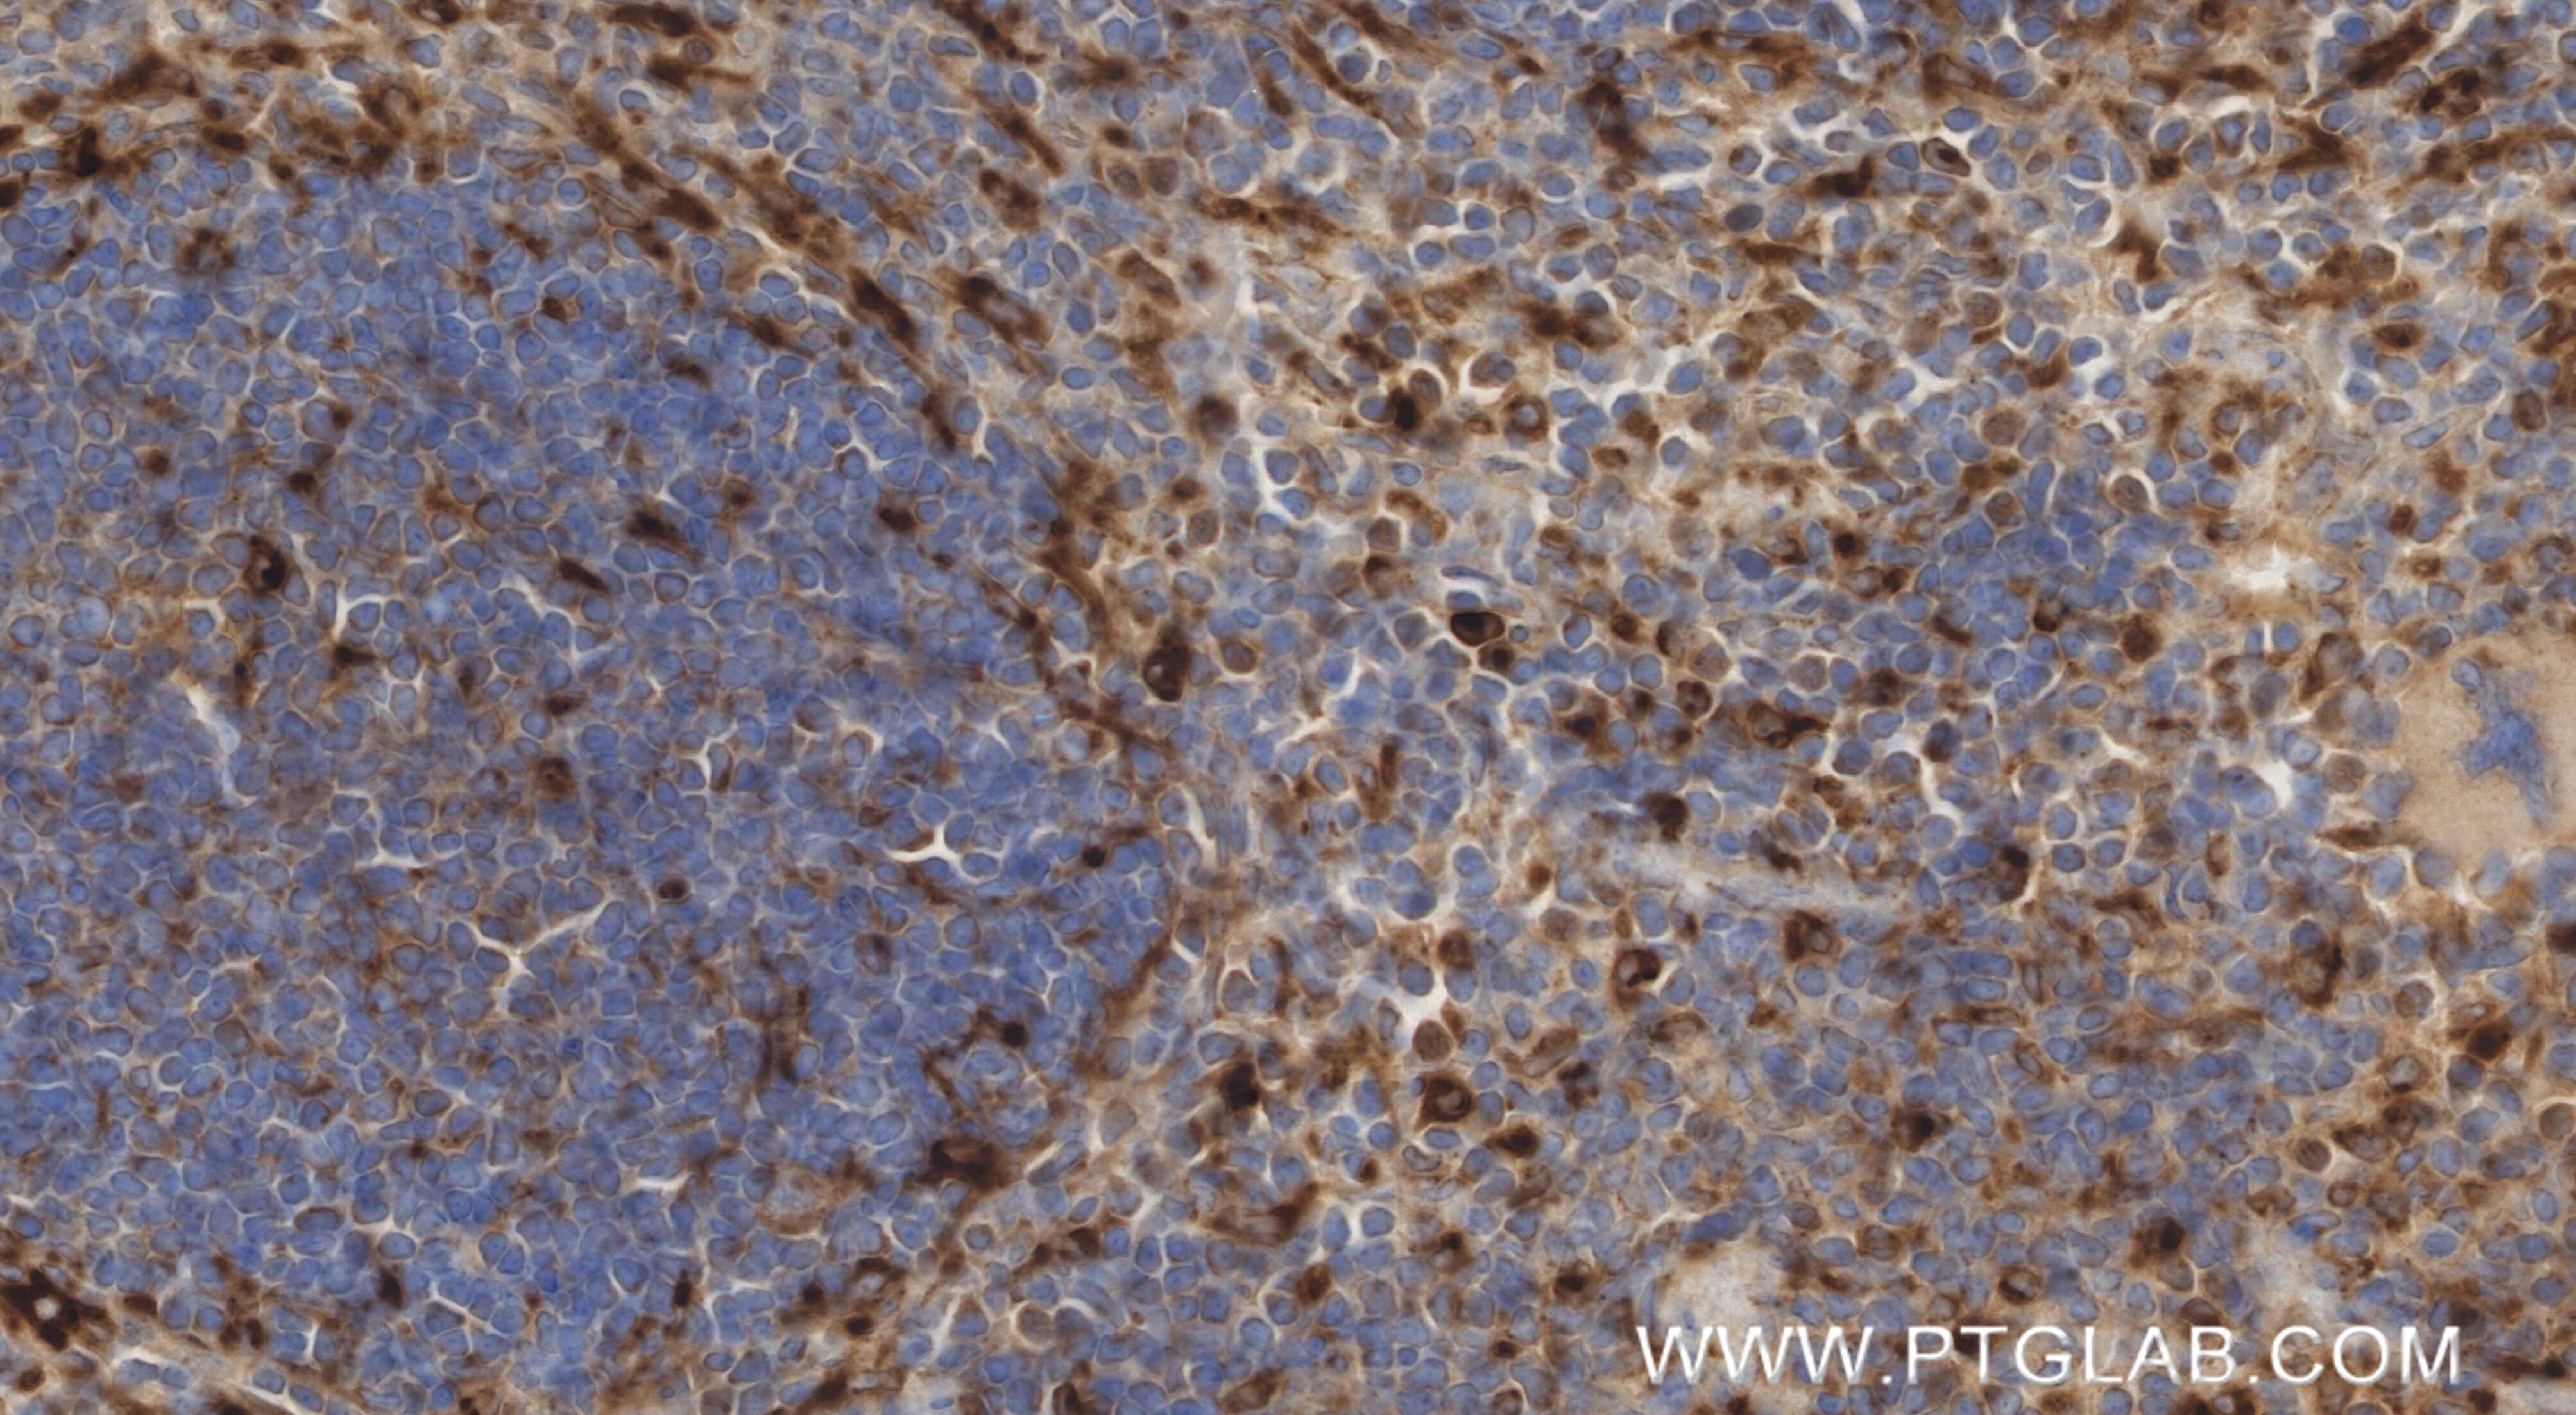
Immunohistochemistry (IHC) staining of mouse spleen tissue using PSAP Recombinant monoclonal antibody (86043-2-RR)

Tested Applications
| Positive WB detected in | NIH/3T3 cells, RAW 264.7 cells, mouse cerebellum tissue, mouse testis tissue |
| Positive IHC detected in | mouse brain tissue, mouse spleen tissue Note: suggested antigen retrieval with TE buffer pH 9.0; (*) Alternatively, antigen retrieval may be performed with citrate buffer pH 6.0 |
| Positive IF-P detected in | mouse brain tissue |
| Positive IF/ICC detected in | NIH/3T3 cells |
Recommended dilution
| Application | Dilution |
|---|---|
| Western Blot (WB) | WB : 1:2000-1:10000 |
| Immunohistochemistry (IHC) | IHC : 1:500-1:2000 |
| Immunofluorescence (IF)-P | IF-P : 1:200-1:800 |
| Immunofluorescence (IF)/ICC | IF/ICC : 1:200-1:800 |
| It is recommended that this reagent should be titrated in each testing system to obtain optimal results. | |
| Sample-dependent, Check data in validation data gallery. | |
Product Information
86043-2-RR targets PSAP in WB, IHC, IF/ICC, IF-P, ELISA applications and shows reactivity with mouse samples.
| Tested Reactivity | mouse |
| Host / Isotype | Rabbit / IgG |
| Class | Recombinant |
| Type | Antibody |
| Immunogen |
CatNo: Eg3155 Product name: Recombinant Mouse PSAP/Prosaposin protein (rFc Tag) Source: mammalian cells-derived, V37 Tag: C-rFc Domain: 17-557 aa of NM_011179.3 Sequence: SPVQDPKTCSGGSAVLCRDVKTAVDCGAVKHCQQMVWSKPTAKSLPCDICKTVVTEAGNLLKDNATQEEILHYLEKTCEWIHDSSLSASCKEVVDSYLPVILDMIKGEMSNPGEVCSALNLCQSLQEYLAEQNQKQLESNKIPEVDMARVVAPFMSNIPLLLYPQDHPRSQPQPKANEDVCQDCMKLVSDVQTAVKTNSSFIQGFVDHVKEDCDRLGPGVSDICKNYVDQYSEVCVQMLMHMQDQQPKEICVLAGFCNEVKRVPMKTLVPATETIKNILPALEMMDPYEQNLVQAHNVILCQTCQFVMNKFSELIVNNATEELLVKGLSNACALLPDPARTKCQEVVGTFGPSLLDIFIHEVNPSSLCGVIGLCAARPELVEALEQPAPAIVSALLKEPTPPKQPAQPKQSALPAHVPPQKNGGFCEVCKKLVLYLEHNLEKNSTKEEILAALEKGCSFLPDPYQKQCDDFVAEYEPLLLEILVEVMDPGFVCSKIGVCPSAYKLLLGTEKCVWGPSYWCQNMETAARCNAVDHCKRHVWN Predict reactive species |
| Full Name | prosaposin |
| Calculated Molecular Weight | 61 kDa |
| Observed Molecular Weight | 65-70 kDa |
| GenBank Accession Number | NM_011179.3 |
| Gene Symbol | Psap |
| Gene ID (NCBI) | 19156 |
| Conjugate | Unconjugated |
| Form | Liquid |
| Purification Method | Protein A purification |
| UNIPROT ID | Q61207 |
| Storage Buffer | PBS with 0.02% sodium azide and 50% glycerol, pH 7.3. |
| Storage Conditions | Store at -20°C. Stable for one year after shipment. Aliquoting is unnecessary for -20oC storage. 20ul sizes contain 0.1% BSA. |
Background Information
Prosaposin (PSAP) is also named as Sulfated glycoprotein 1 (SGP-1). PSAP is a secreted neurotrophic factor and a lysosomal protein serving as the precursor of saposins (A-D), which are cofactors for hydrolases of sphingolipids (PMID: 25130661, PMID: 31220974). PSAP modulates glycosphingolipid metabolism and variants have been linked to Parkinson's disease (PD) (PMID: 37726325). As a dual-function protein, PSAP is a lysosome-associated protein that participates in a variety of cellular processes. In the lysosome, PSAP is processed to activate enzymes that degrade lipids. PSAP proteins located extracellularly are involved in cancer progression, such as proliferation and tumor death suppression signaling (PMID: 39405903). Prosaposin (PSAP) has two forms: a precursor and a secreted form. The secreted form has neurotrophic, myelinotrophic, and myotrophic properties. The precursor form is a precursor protein of saposins A-D (PMID: 33242172). Both human and mouse prosaposin are 65-70 kDa proteins cleaved in the lysosomes into four 10-15 kDa proteins designated saposins A, B, C and D (PMID: 8573994). Sulfated glycoprotein-1 (prosaposin) exists in 2 forms: a 65 kDa form targeted to lysosomes and a post-translationally modified to the 70 kDa form secreted extracellularly (PMID: 8593668).
Protocols
| Product Specific Protocols | |
|---|---|
| IF protocol for PSAP antibody 86043-2-RR | Download protocol |
| IHC protocol for PSAP antibody 86043-2-RR | Download protocol |
| WB protocol for PSAP antibody 86043-2-RR | Download protocol |
| Standard Protocols | |
|---|---|
| Click here to view our Standard Protocols |